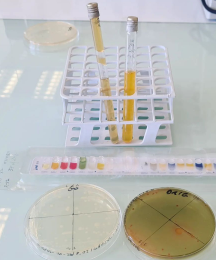
Image

Le Bac STL
Une formation variée et cohérente
Alternance de la formation entre les enseignements généraux et les enseignements technologiques comportant une part importante d’activités expérimentales.
Étude des sciences appliquées en laboratoire et en métrologie dans les domaines : énergie, produits chimiques, pharmaceutiques et agroalimentaires, textiles, aéronautique, analyse médicale et biologique, traitement (eaux, déchets, pollution, air…), météorologie. . .
Deux spécialités :
le choix de la spécialité se fait dès la classe de 1ère
- biotechnologies : étude des systèmes vivants, identification de micro-organismes, diagnostic médical, analyse et contrôle de bioproduits, étude de l’environnement ;
- sciences physiques et chimiques en laboratoire : étude des sciences appliquées en laboratoire et en métrologie dans divers domaines industriels (énergie, produits chimiques, pharmaceutiques
et agro-alimentaires, textiles, aéronautique, analyse médicale et biologique, traitement et dépollution, météorologie, etc.).
En 1ère, l’enseignement comprend 3 modules consacrés à l’image, la chimie et le développement durable, l’ouverture vers le monde de la recherche et de l’industrie d’une part et à un projet d’autre part.
En terminale, la progression pédagogique est organisée autour de 3 thèmes : l’habitat, le transport et la santé.
Série accessible à tous les élèves de 2nde même si aucun enseignement technologique optionnel n'a été suivi.
Enseignements technologiques optionnels conseillés pour conforter les élèves dans leur choix de la série STL :
- biotechnologies ;
ou
- sciences et laboratoire.